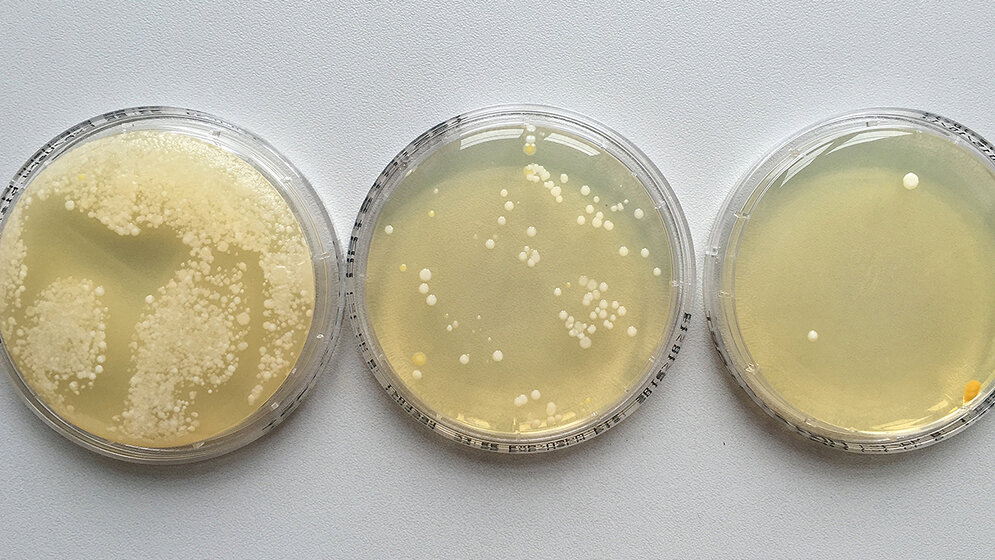
Hygieneprojekt Händehygiene

Die Idee, den Mikrobiologieunterricht etwas praxisbezogener zu gestalten, ließ mich nicht los. So sprach ich unsere Hygieneabteilung an, um eine Zusammenarbeit anzustreben. Die Vorteile lagen auf der Hand, meine MTA-Auszubildenden sollten mehr Praxiserfahrung erhalten, und den Mitarbeitern im Haus sollte die Compliance der Hände- und Flächendesinfekton ins Gedächtnis gerufen werden.Labor etwas näher kennen- und schätzen lernen. Immerhin werden circa 80 % aller Diagnosen und Therapien auf Grundlage von Untersuchungen durch eine MTA in einem Laboratorium erstellt beziehungsweise überprüft. In der täglichen Arbeit besitzt die Hygiene einen sehr hohen Stellenwert und geht doch so oft im hektischen Arbeitsalltag verloren. Mein Kollege Stefan Drees war von der Idee angetan, so machten wir uns an die Arbeit, ein Konzept zu entwickeln. Wir waren uns einig, dass alles auf freiwilliger Basis geschehen sollte und keiner Sanktionen befürchten musste, egal wie die Ergebnisse der Handabklatschproben sein würden.
Mit intensiver Kommunikation konnten wir unsere Geschäftsführung und Pflegedirektion davon überzeugen, der erste Schritt war getan. Das Hygieneprojekt wurde ein Teil des Mikrobiologieunterrichts. Als Vorbereitung, im Unterricht, nahmen wir gegenseitig Abklatschproben von unseren eigenen Händen (siehe Foto, nicht gewaschene Hände, gewaschene Hände, desinfizierte Hände). Nach dieser Vorbereitung und etwas Übung gingen meine Auszubildenden auf Station und nahmen die ersten Handabklatschproben, zunächst begleitet von großer Skepsis der Mitarbeiter. Sie befürchteten Konsequenzen, aber nach gutem Zureden und Sicherstellung der Anonymität waren sie zur Mitwirkung bereit.
Die MTA-Auszubildenden protokollierten die jeweilige Arbeitssituation, in der die betreffende Person sich befand, auf welcher Station sie arbeitet und den Namen auf ein eigens dafür erstelltes Formular mit einer Nummer. Die Probe bekam nur die Labornummer. Nach Abdruck der Hände wurden sie explizit darauf hingewiesen, sich die Hände nun zu waschen und zu desinfizieren, immerhin waren sie mit einem Nährmedium in Kontakt gekommen, und dieses bietet optimale Bedingungen zum Wachstum von Bakterien. Die Neugierde war geweckt. „Wann bekommen wir die Ergebnisse?“, war die erste Frage, die gestellt wurde. Die Probanden mussten sich allerdings 48 Stunden gedulden.
Nach 48 Stunden wurden die Nährmedien (Caso-Agar) aus dem Brutschrank geholt und beurteilt. Meistens handelte es sich um die Normalflora der Haut (Staphylococcus spp., apathogene Corynebakterien, Mikrokokken et cetera).
Fazit
Dieser erste „Ausflug“ in die reale Arbeitswelt liegt nun vier Jahre zurück und ist inzwischen zu einer festen Bestandsgröße im Mikrobiologieunterricht geworden.
* MTA-Lehrkraft, stellv. Schulleitung MTA-Schule, St. Elisabeth Krankenhaus Köln-Hohenlind, marina.geisen@hohenlind.de
Entnommen aus MTA Dialog 9/2019
Artikel teilen